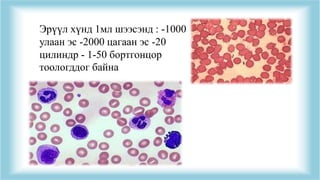
Эрүүл хүнд 1мл шээсэнд : -1000
улаан эс -2000 цагаан эс -20
цилиндр - 1-50 бортгонцор
тоологддог байна

Recommended
PPTX
Шээсний тундасын шинжилгээ.pptx
PPTX
PPTX
Boornii dutagdal yaraltai tuslamj
PPTX
бөөр шээс бэлгийн замын тогтолцооны гаж хөгжил.Pptx сосоо
PPTX
бөөр ялгаруулах тогтолцооны эмгэг
PPTX
ходоод улаан хоолойн сөөргөө өвчин
PPTX
Жирэмслэлт ба зүрх судасны өвчин
PPTX
PPT
амьсгал эрхтний онцлог 2013
DOCX
Уушгины архаг бөглөрөлтөт өвчин
PPT
PPTX
кардиомиопати, зүрхний архаг дутагдал
PPTX
PPTX
ходоод,дээрх гэдэсний шархлаа өвчин
PPTX
PPT
PPT
Нойр булчирхайн архаг үрэвсэл
PPTX
шээсний ерөнхий шинжилгээ
PPT
Communicable diseases lection 4-6
DOCX
PPTX
умайн хүзүүний хорт хавдар
PPTX
PPTX
PPT
PPT
биений юмны үйл ажиллагааны алдагдал
PPTX
Lecture 9 bodisiin soliltsoo
PPTX
Нарийн гэдэсний гистологи
PPT
PPTX
8.hepatorenal tuwshinbayar
PPTX
2.4 Кесар зүслэгээр төрөх арга
More Related Content
PPTX
Шээсний тундасын шинжилгээ.pptx
PPTX
PPTX
Boornii dutagdal yaraltai tuslamj
PPTX
бөөр шээс бэлгийн замын тогтолцооны гаж хөгжил.Pptx сосоо
PPTX
бөөр ялгаруулах тогтолцооны эмгэг
PPTX
ходоод улаан хоолойн сөөргөө өвчин
PPTX
Жирэмслэлт ба зүрх судасны өвчин
PPTX
What's hot
PPT
амьсгал эрхтний онцлог 2013
DOCX
Уушгины архаг бөглөрөлтөт өвчин
PPT
PPTX
кардиомиопати, зүрхний архаг дутагдал
PPTX
PPTX
ходоод,дээрх гэдэсний шархлаа өвчин
PPTX
PPT
PPT
Нойр булчирхайн архаг үрэвсэл
PPTX
шээсний ерөнхий шинжилгээ
PPT
Communicable diseases lection 4-6
DOCX
PPTX
умайн хүзүүний хорт хавдар
PPTX
PPTX
PPT
PPT
биений юмны үйл ажиллагааны алдагдал
PPTX
Lecture 9 bodisiin soliltsoo
PPTX
Нарийн гэдэсний гистологи
PPT
Viewers also liked
PPTX
8.hepatorenal tuwshinbayar
PPTX
2.4 Кесар зүслэгээр төрөх арга
PPTX
PPTX
PPTX
PDF
PPTX
INNOMED - 2015 Lkhagvasuren_SHUTIS
PPTX
бэлгийн хромосомын эмгэгүүд
PPTX
PPTX
Innomed-2014 Уралдаан ШУТИС 4-р курс
PPTX
Noir bulchirhain tsochmog urewsel
PPTX
PPTX
PPTX
PPT
PPTX
PPT
Blok 17.-hepatobiliary-and-pancreatic-disorders-0309
PPTX
PPTX
PPTX
Similar to Амбуржийн арга
PPTX
Kidney_Biochemical_Examination_Mongolian.pptx
PPTX
PDF
шинжилгээ өгөхөд анхаарах зүйл
DOCX
DOCX
DOCX
DOCX
DOCX
DOCX
DOCX
PDF
DOCX
Eronhii emchiin jishig soril 1
DOCX
Eronhii emchiin jishig soril 1
PPTX
DOCX
PPTX
DOCX
PPTX
PDF
Архаг пиелонефритийн эмчилгээнд “Бөөрний зэхмэл” бэлдмэлийг хэрэглэсэн дүн
DOCX
Амбуржийн арга 1. 3. 4. 5. 6. Ажилбар
1. Шинжилгээнд ирсэн
шээсийг шилэн
бортгонд юүлж
хэмжинэ
2. Шээсийг холиод
хуруу шилэнд 10.0мл
шээс соруулаар авч
центрфугт 5
минут(2000эргэлт/мин)
эргүүлнэ
3. Дээд шингэнийг
соруулж асгаад 1.0мл
тунадас үлдээнэ
4. Тунадасаа холиод
торонд дүүргэж 5
минутын дараа торны
бүх талбайд улаан эс,
цагааи эс, цилиндрийг
тоолно.
7. Тооцоолол
H = (X *1000)/S * (V/T)
H - 1 минутанд ялгарсан эс, элементийн тоо
X - 1,0 мкл-т байх тоо
V - Шээсний хэмжээ
S – Хуруу шилэнд авсан шээсний хэмжээ
T – Шээс цуглуулсан хугацаа (мин)
8. 10. 12. 13. 14. Шээсний хувийн жин
• Шээсний хувийн жин нь
нэрмэл устай, шээсний
бүрдлийн хэсгүүдийн тоо
болон хэмжээг
харьцуулсан жин юм.
15. хэвийн насанд хүрэгчдийн
шээсний хувийн жин нь 1,016-
1,022 байдаг хэдий ч хэвийн үйл
ажиллагаатай бөөрнөөс ялгарах
шээсний хувийн жин нь 1,003-
1,035 хэмжээтэй байдаг.
16. Хувийн жин багатай буюу 1,007- аас багагүй жинтэй шээсийг
гипостенурик (hyposthenuric) гэнэ.
Чихрийн шижингийн үед шээсний хувийн жин 1,001 байдаг.
17. 18. Бөөрний дээд булчирхайн үйл ажиллагаа алдагдах, элэгний өвчлөл,
зүрхний хэт ачаалал мөн усны илүүдлийн үед шээсний хувийн жин
өндөр байдаг.
19. 20. 21. • Ажилбар
• Найман шилэнд цуглуулсан шээс бүрийн хэмжээг
хэмжээтэй бортгонд хэмжиж, хувийн жинг урометрээр
хэмжиж тэмдэглэнэ.
Тооцоолол
• Өдөр, шөнийн шээсний
хэмжээ, хувийн жин,
харьцааг гаргана.
22. Лавлах хэмжээ
• Хоногт хэрэглэсэн шингэний 75% нь шээсээр ялгарна.
• Өдрийн шээсний хэмжээ шөнийн шээсний хэмжээнээс
давамгайлна. (3:1)
• Аль нэг шээсний хувийн жин 1020-1022 хүрнэ.
• Тухайн нэг шээсний хэмжээ хувийн жингийн хамаарал
урвуу байна.
23. Эмнэл зүйн хэрэглэл
• Бөөрний түүдгэнцэрийн гэмтлийн улмаас анхны шээс
үүсэх явж алдагдана.
• Бөөрний суваганцарын гэмтлийн үед шээсийг өтгөрүүлэх
үйл ажиллагаа хямарна.
• Бөөрний дутагдлын үед шөнийн шээсний хэмжээ
өдрийнхөөс давамгайлж эхлэнэ.
24. 25. 26. • Бөөр болон шээсний замыг үрэвсэлт өвчнийг оношлох
зорилготой шинжилгээ юм . Зөвхөн өглөөний өлөн
шээсний дунд хэсгээс цэвэр хуурай шилэнд авч
шинжилгээнд өгнөө .
27. Өгсөн шээсийг тундасжуулж 1мл
шээсэндэх дүрст элемэнтүүдийг
судалдаг байна
Хэрэглэгдэх багаж хэрэгсэл:
1. Микроскоп 2. Тоолуурийн тор
3.хуруу шил 4. Хуруу шилний
тавиур 5. Шилэн савх 6. Соруул
28. Эрүүл хүнд 1мл шээсэнд : -1000
улаан эс -2000 цагаан эс -20
цилиндр - 1-50 бортгонцор
тоологддог байна